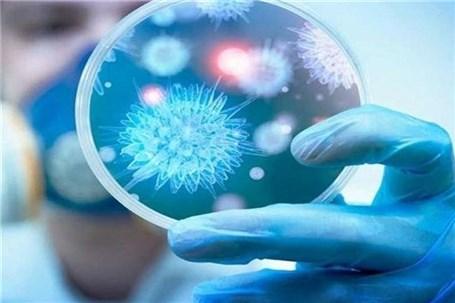

تصویب تحت پوشش بیمه قرار گرفتن بیماران کرونایی
عضو کمیسیون بهداشت مجلس خبر داد:
تصویب تحت پوشش بیمه قرار گرفتن بیماران کرونایی
عصر اعتبار- عضو کمیسیون بهداشت مجلس شورای اسلامی گفت: به کمک وزیر و شورای عالی بیمهها تصویب شد که از این پس تمام دارو و درمان بیماران کرونایی و حتی اقلام یکبار مصرف مورد نیاز آنها تحت پوشش بیمه ها قرار گیرد.
نسخه قابل چاپ
جمعه ۲۳ آبان ۱۳۹۹ - ۱۰:۰۹:۰۰
به گزارش پایگاه خبری «عصر اعتبار» به نقل از ایسنا، دکتر یحیی ابراهیمی اظهار کرد: به سمت فصل سرد میرویم و بیماری کرونا ویروس میتواند با آنفلوآنزا همپوشانیداشته باشد و شدت بیماری و شیوع آن افزایشی چندین برابر داشته باشد.
وی با بیان اینکه بیمارانی که دارای بیماری زمینهای ریوی، قلبی و عروقی، کلیپی، فشارخون و یا بیمارانی که کورتن استفاده میکنند بایدتحت درمان قرار گیرند تا چنانچه دچار کرونا ویروس شدند فوت نکنند، افزود: باید تعداد تستها و نمونهگیریها را افزایش داده وهدفمند کنیم.
عضو کمیسیون بهداشت مجلس شورای اسلامی گفت: نباید افرادی که بیماریهای زمینهایدارند بخاطر ترس از کرونا در خانه بمانند و به وضعیت حادتری دچار شوند بلکه بایدنسبت به درمان خود از طریق پزشک متخصص اقدام کنند.
ابراهیمی بیان کرد: ضرورت دارد این افراد به هر طریقی پایش شوند.
نماینده مردم سلسله و دلفان با اشاره به اینکه در ستاد کرونای استان توصیه شده تعداد تستها را افزایش و هدفمند انجام دهیم وافرادی که مثبت هستند را قرنطینه کنیم نه اینکه رها شوند، تصریح کرد: ضرورت دارد افراد مثبت را غربالگری کرد و پس از پایش آنها رادر نقاهتگاهها به مدت دو هفته از دیگران جدا و تحت درمان قرار گیرند.
عضو کمیسیون بهداشت مجلس شورای اسلامی با بیان اینکه یکی از اعتراضات بنده درستاد کرونا این بود که درمان بیماران کرونایی تحت پوشش بیمهها نبود و بصورت آزاد اینامر انجام و فرد متحمل ۴۰ میلیون تومان هزینه درمان میشد، افزود: خوشبختانه به کمکوزیر و شورای عالی بیمهها تصویب شد که زین پس تمام دارو و درمان بیماران کرونایی وحتی اقلام یکبار مصرف مورد نیاز آنها تحت پوشش بیمه ها قرار گیرد.
ابراهیمی گفت: در حال حاضر مشکل آنچنانی برای درمان بیماران کرونایی نداریم و به لحاظ دارو نیز محدودیت نداریم.
وی از تلاش مجاهدانه و جهادی کادر درمان و پرستاری که با دستمزد کم به مردم خدمت میکنند تقدیر کرد.
اخبار مرتبط
دیگر اخبار این روز
حق کپی © ۲۰۰۱-۲۰۲۶ - Sarkhat.com - درباره سرخط - آرشیو اخبار - جدول لیگ برتر ایران